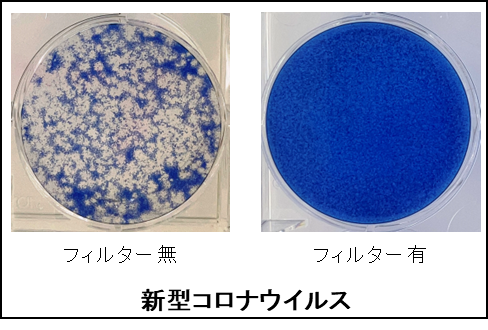
捕集溶液によるウイルス感染価測定（１）
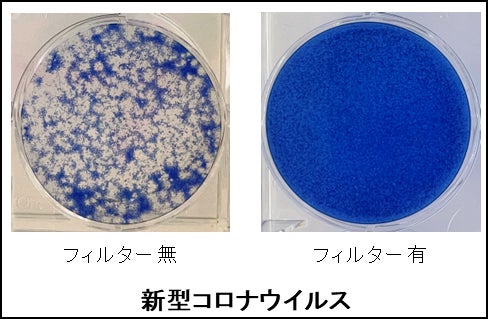
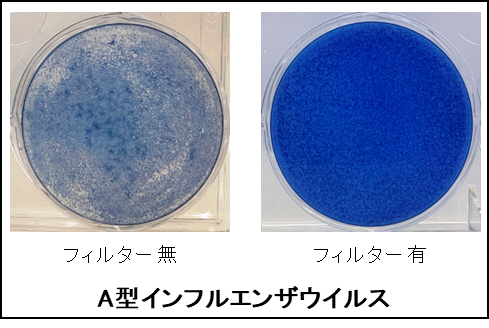
捕集溶液によるウイルス感染価測定（２）

当社の全館空調システムに搭載している専用HEPAフィルターは新型コロナウイルス・インフルエンザウイルスの捕集率が99.98%以上であることを確認
~一般財団法人日本繊維製品品質技術センターと共同で実証~
▶当リリースの本文はこちら:https://prtimes.jp/a/?f=d22927-136-740bc120ff9f3f048cc89f518b98184f.pdf
▶当社の全館空調システムの詳細はこちら:https://homes.panasonic.com/sumai/lifestyle/airlohas/
当社の全館空調システムは、専用エアコン1台で、居室だけでなく廊下や洗面室等の非居室空間も含めた全館を換気・空調するシステムで、室内を循環する空気は、PM2.5※Bをはじめ、0.3μmの微粒子を99.97%以上捕集できる※C高性能な「HEPAフィルター」で浄化される機能も併せ持っています。
これまで、「HEPAフィルター」は、ホコリ、花粉、PM2.5を捕集できることを確認していましたが、近年変化した生活者の空気に関する価値観に応え、より安全・安心な空気環境を提供できることを確認するため、このたびウイルスに対する捕集効果を検証しました。
今回、「HEPAフィルター」単体におけるウイルス捕集効果が検証できましたが、今後は、全館空調システムで換気・空調される空間におけるウイルス捕集効果についても、検証を行う予定です。
捕集溶液によるウイルス感染価測定(1)
捕集溶液によるウイルス感染価測定(1)
捕集溶液によるウイルス感染価測定(2)
捕集溶液によるウイルス感染価測定(2)
フィルター通過後の捕集溶液を細胞に播種・培養し、ウイルス感染により細胞が変性した領域(プラーク)の数を数えることでウイルス感染価(PFU/mL)を測定比較。HEPAフィルター有では、青く染色される正常細胞が多く保持され、フィルター無に比べて、変性細胞が少ないことを示しています。すなわち、HEPAフィルターがウイルス捕集に有効に作用していることが確認できます。
◎当社の全館空調システムの詳細はこちら
https://homes.panasonic.com/sumai/lifestyle/airlohas/
※A: 一定の試験条件下におけるHEPAフィルター濾材の捕集効果を示しており、空間における捕集効果を示すものではありません。また、HEPAフィルターは、ウイルスの働きを抑制することや、病気の治療や予防を目的とするものではありません。
※B: PM2.5は粒径が2.5μm(マイクロメートル)以下の微小粒子状物質の総称。1μmは1mmの1000分の1。
※C: HEPAフィルターの性能値。工場出荷時の初期性能になります。換気・空調システム全体の数値を示すものではあリません。また、0.3µm未満の微小粒子状物質については捕集の確認ができていません。

このプレスリリースには、メディア関係者向けの情報があります
メディアユーザー登録を行うと、企業担当者の連絡先や、イベント・記者会見の情報など様々な特記情報を閲覧できます。※内容はプレスリリースにより異なります。
すべての画像
